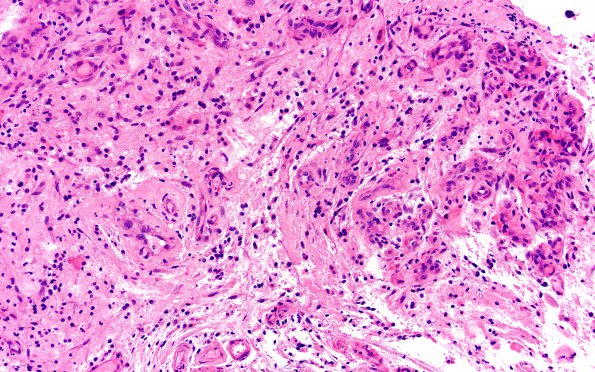
15B5 CRV (Case 15) A1 H&E 20X 2

Table of Contents
Washington University Experience | MYELIN (NON-IMMUNE MEDIATED) | Retinal Vasculopathy with Cerebral Leukoencephalopathy (RVCL, TREX1 Mutation) | 15B5 CRV (Case 15) A1 H&E 20X 2
15B5,6 Numerous clusters of microvessels are shown, a number with slight collagenous thickening (H&E).